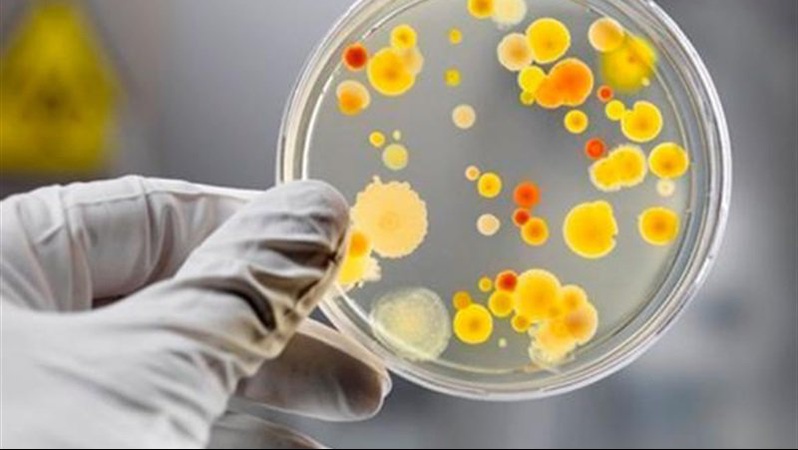
На Волині зареєстрували 7 випадків сальмонельозу та 2 випадки ботулізму

Неділя, 14 червня 2026


Сьогодні, 9 вересня, близько 18-ї години на одній із транспортних розв’язок Луцька сталась ДТП — зіткнулись два легковики

29 серпня в Україні вшановують пам’ять загиблих захисників

За минулий тиждень на Волині виявили 7 випадків сальмонельозу та 2 випадки ботулізму. Ще 48 волинян звернулись з укусами кліщів.
Про це інформує обласний лабораторний центр.
Протягом тижня фахівцями ДУ «Волинський обласний центр контролю та профілактики хвороб МОЗ України» по екстрених повідомленнях в області зареєстровано:
За даними моніторингу на минулому тижні у Волинській області захворюваність на гострі респіраторні вірусні інфекції знаходилась на сезонному рівні. Інтенсивний показник захворюваності на 100 тисяч населення склав 142,4 та був нижче епідемічного порогу на 75%. За останній тиждень, у порівнянні з попереднім, захворюваність знизилась на 13%. У структурі захворюваності діти становлять 60%.
Близько чотирьох відсотків від загальної кількості захворілих госпіталізовано.
Попередній допис
Наступний допис
©2026 uaGit

Коментарі